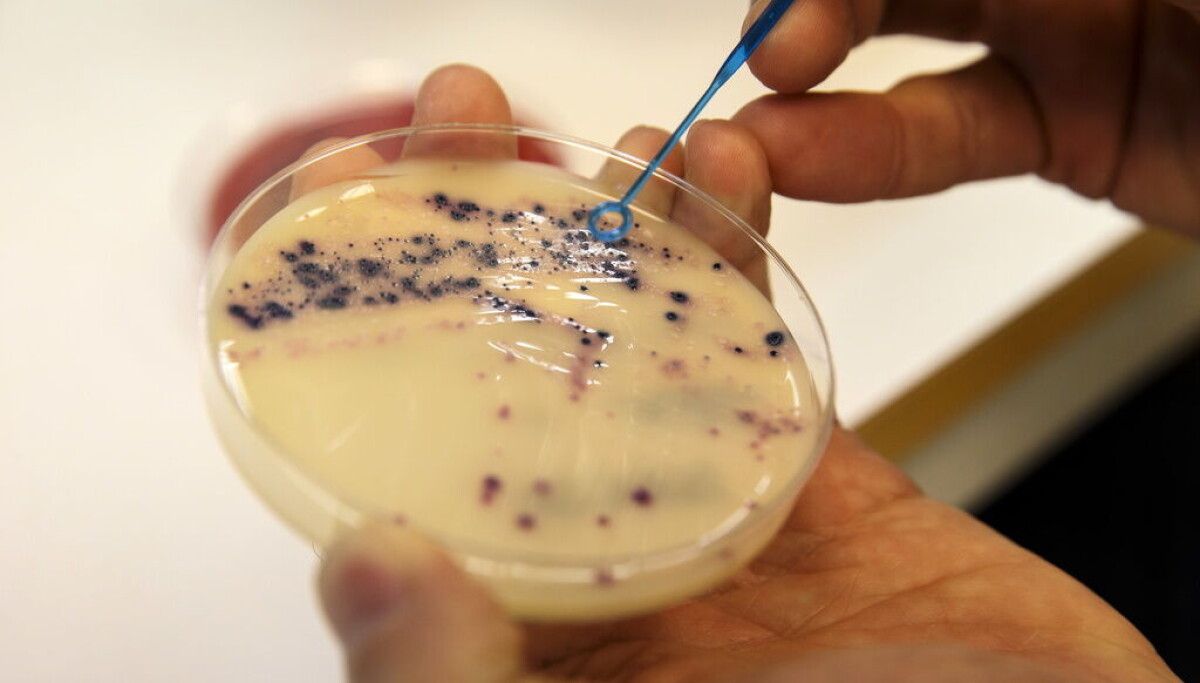
Svensk studie visar lovande resultat för nytt vapen mot antibiotikaresistens: Så här kan det rädda framtiden! Svensk studie visar lovande resultat för nytt vapen mot antibiotikaresistens: Så här kan det rädda framtiden!

Topp 5 anledningar till varför amerikanska chipjätten överträffar norska oljefondens investeringar
Norska oljefondet investerar i amerikansk chipjättes teknik I den snabba teknologiska utvecklingen är det som många inte alltid är medvetna om att investeringar ofta kan leda till oväntade resultat och möjligheter. Det norska oljefondet, en av världens största investeringsfonder, har nyligen ökat sina investeringar i den amerikanska chipjätten NVIDIA. Detta kan få stora konsekvenser för […]